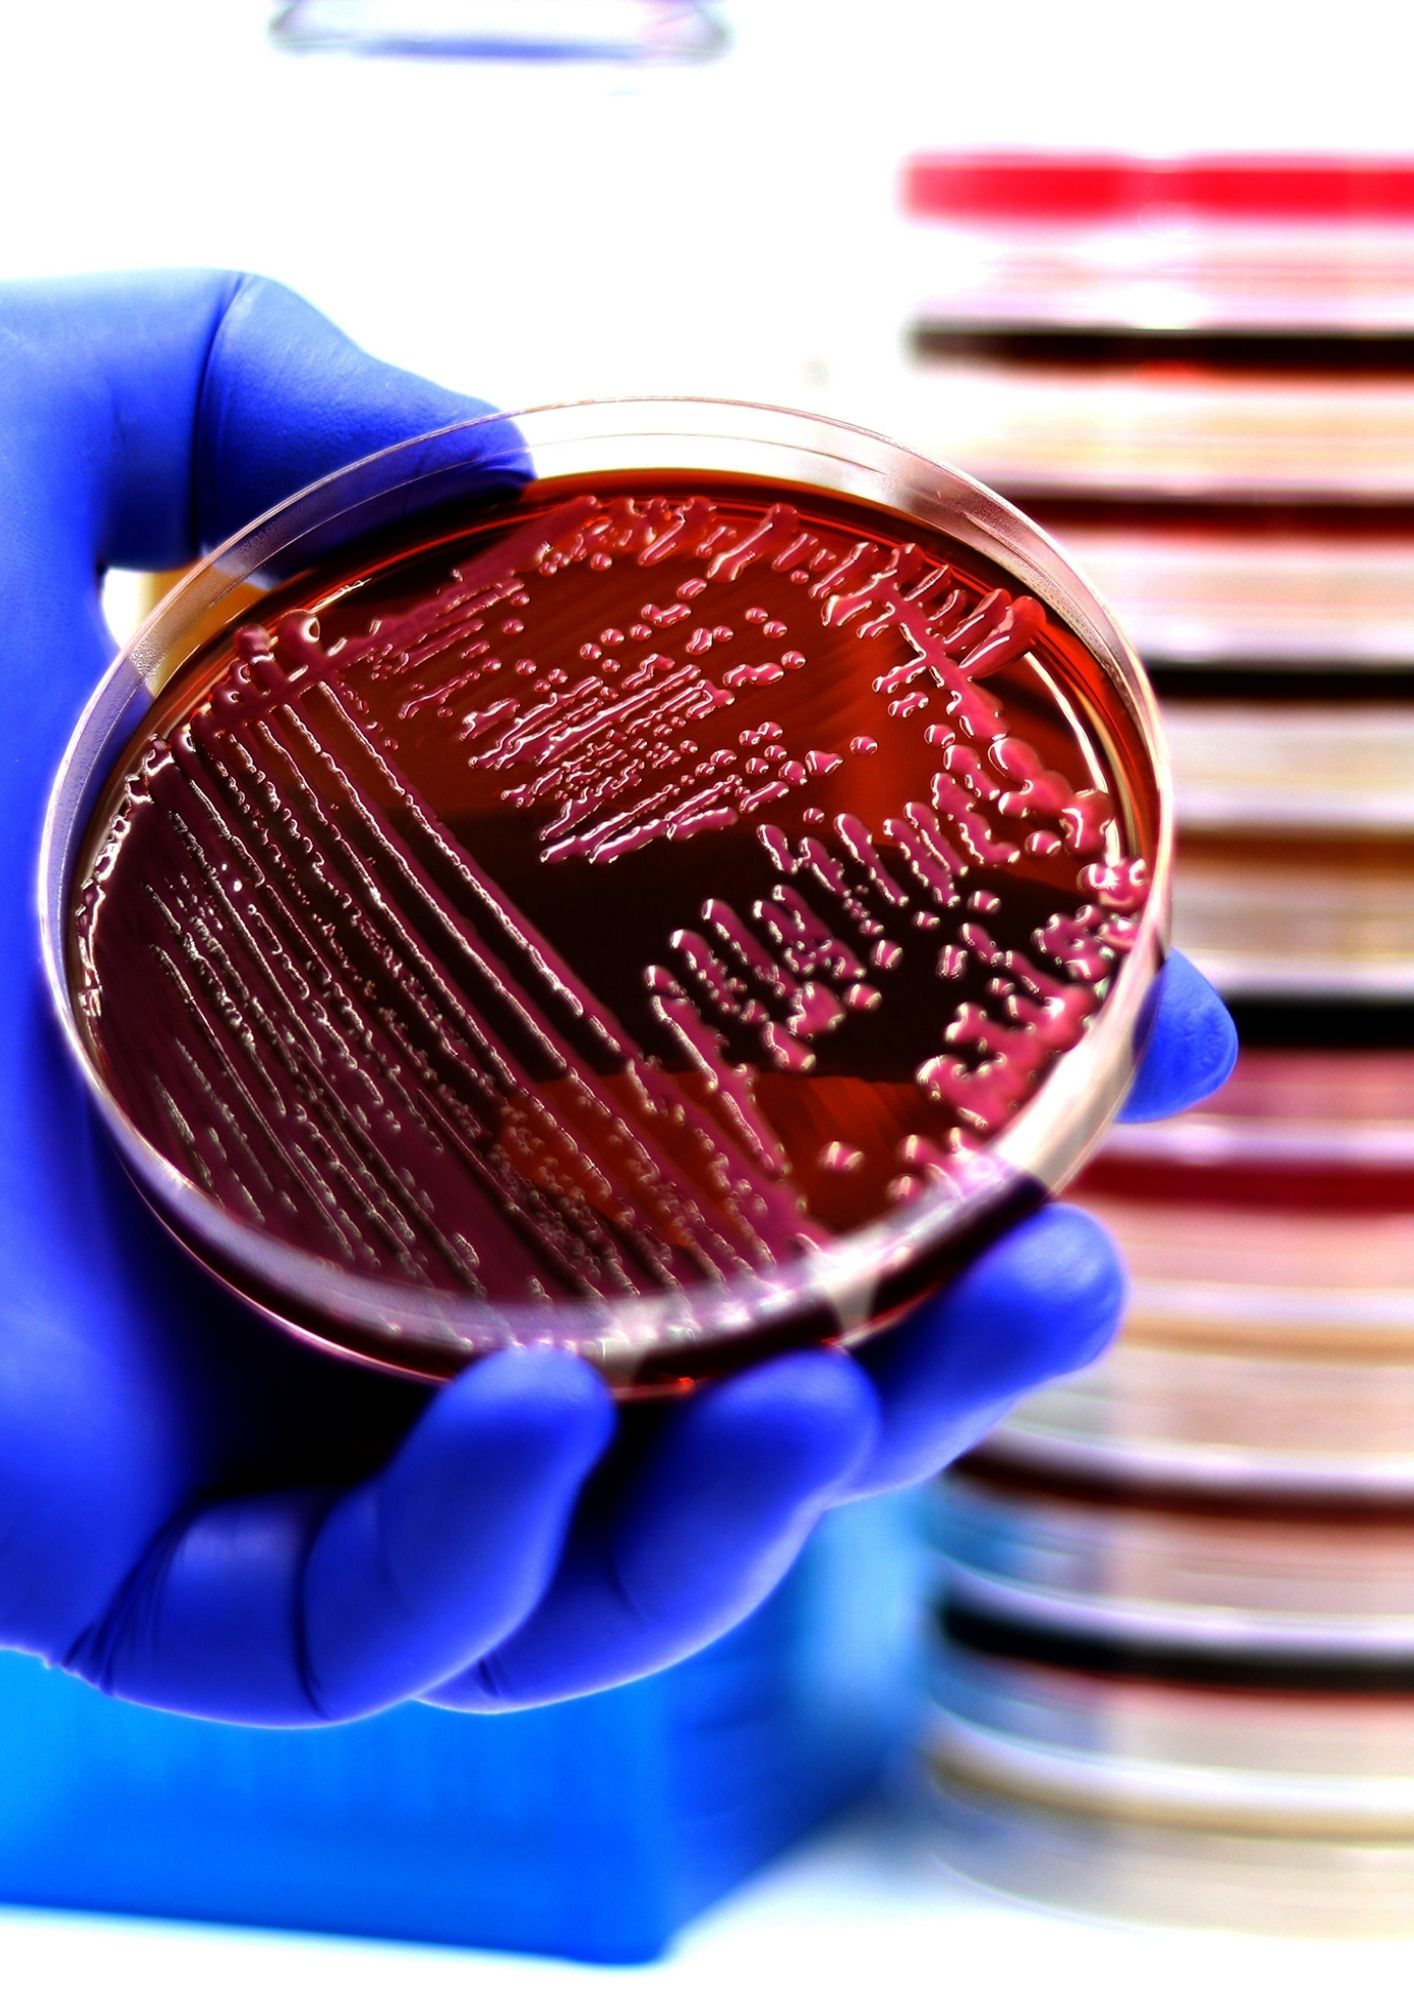
diseño sin título (11) diseño sin título (11)

Analítica Veterinaria
Más de 30 años de experiencia en diagnóstico laboratorial al servicio del veterinario clínico y la sanidad animal.
¿Quiénes somos?
Analítica Veterinaria es un laboratorio de diagnóstico con más de tres décadas de experiencia en el análisis, investigación y apoyo clínico en enfermedades animales.
Desde nuestros inicios, hemos trabajado con un objetivo claro: ofrecer un servicio analítico fiable, cercano y orientado a la práctica veterinaria real.
La colaboración directa con veterinarios clínicos y el conocimiento acumulado a lo largo de los años nos permiten aportar soluciones diagnósticas útiles y aplicables en el día a día.

¿Qué hacemos?
Proporcionamos servicios de diagnóstico laboratorial veterinario que abarcan distintas áreas analíticas, combinando tecnología avanzada, experiencia técnica y criterio clínico.
Nuestro trabajo no se limita a emitir resultados:
ofrecemos interpretación diagnóstica y asesoramiento especializado para facilitar la toma de decisiones sanitarias y mejorar el manejo clínico y productivo de los animales.
Áreas diagnósticas y control de calidad
Nuestro servicio incluye, entre otras, las siguientes áreas:
Microbiología, parasitología, virología, serología, biología molecular, hematología, bioquímica y anatomía patológica.
Todas las técnicas empleadas están sometidas a controles de calidad internos y externos, garantizando resultados fiables, reproducibles y clínicamente útiles.
Compromiso con el veterinario
Trabajamos en colaboración estrecha con el profesional veterinario, ofreciendo:
Por qué elegir Analítica Veterinaria
Compromiso, experiencia y rigor diagnóstico al servicio del veterinario clínico.

Más de 30 años de experiencia en sanidad animal

Equipo técnico y veterinario altamente cualificado

Resultados rápidos, precisos y fiables

Asesoramiento veterinario especializado
¿Necesita apoyo diagnóstico para sus casos clínicos?
Estamos a su disposición para ayudarle en la interpretación de resultados y en la elección de las pruebas más adecuadas.
